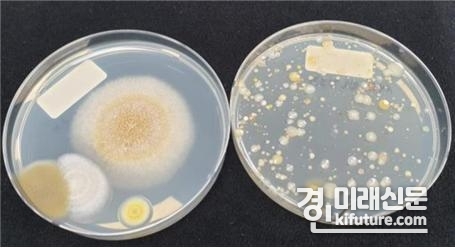

(경인미래신문=조영현 기자) 경기도농업기술원 버섯연구소는 느타리, 표고 등 도내 180개 버섯재배 농가에 버섯 유해균 밀도를 측정하고 진단할 수 있는 미생물 자가진단배지를 배포한다고 7일 밝혔다.
농가에 제공하는 자가진단배지는 오염을 일으키는 유해균의 밀도조사를 위한 미생물배지로 곰팡이 측정용, 세균 측정용으로 구분된다.
자가진단은 무균기(크린부스), 접종실, 배양실 등 조사가 필요한 농가 시설에서 공중에서 자연적으로 떨어지는 균(낙하균)을 수집 후 농가배양실에서 3~4일 배양하면 유해균의 밀도 측정이 가능한 간단한 방법이다.
측정용 배지 이외에 다른 기구가 필요하지 않아 농가에서도 쉽게 할 수 있고 유해균의 밀도를 눈으로 직접 확인할 수 있는 장점이 있다.
경기도농업기술원 버섯연구소는 2013년부터 버섯 병해 발생 감소를 위해 농가의 시설배치, 버섯배지의 살균조건, 공조시설관리방법 등 오염 저감을 위한 연구를 꾸준히 수행하는 한편 병 발생 농가의 의뢰를 통해 오염 발생 원인분석, 시설관리방법, 병 진단 등 컨설팅을 지속적으로 진행하고 있다.
자가진단배지 제공은 농가 스스로 오염을 일으키는 유해균을 직접 눈으로 확인하고 청결한 시설관리를 하기 위한 것으로 농가에서 요청할 경우 지속적으로 제공할 예정이다.
도농기원은 오염실태 설문조사 결과를 바탕으로 농가에서 인식하지 못하고 있는 오염발생 문제점을 파악해 주기적인 교육과 현장컨설팅도 실시하기로 했다.
아울러 오염 현황, 시설의 문제점, 작업자의 문제점 등 오염발생 원인 분석을 위해 5월 한 달 동안 농가의 병해 발생 감소를 위한 오염실태 설문조사를 실시하고, 예방체계를 마련할 예정이다.
정구현 버섯연구소장은 “도내 버섯농가 오염 발생의 가장 큰 원인은 버섯균 배양 및 생육과정에서 유입되는 외부 유해균의 침입”이라며 “농가에서는 청결 유지를 위해 스스로 주기적인 유해균 밀도 측정이 반드시 필요하다”고 말했다.
























